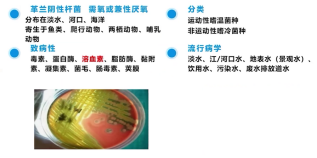
image.png

查看更多
密码过期或已经不安全,请修改密码
修改密码
壹生身份认证协议书
同意
拒绝
同意
拒绝
同意
不同意并跳过
27岁青年男性,主诉咳嗽伴乏力3+天,发热1+天。
患者3天前受凉后出现咳嗽、乏力症状,于当地诊所自行购药(具体药名不详),服药后症状无明显好转;入院前1天出现发热(未测量体温),同时伴胸痛、喘息、气促及痰中带血表现。患者因出差途中发病,遂于当地人民医院完善胸部CT检查,提示右上肺叶病变,建议转上级医院诊疗,后未在当地进一步处理,直接转至我院急诊科就诊。
吸烟史4年,每日1包;饮酒史5年;余无特殊。
查体:患者呈低热状态,体温37.5℃,脉搏增快,心律齐,呼吸25次/分,血压平稳。未吸氧时血氧饱和度仅78%,处于严重低氧状态,但意识清醒,皮肤黏膜无异常,未见皮疹、瘀点瘀斑,肝掌、蜘蛛痣等体征缺如。听诊可闻湿啰音,未及哮鸣音,心腹查体无阳性体征,双下肢无水肿。
实验室检查:白细胞计数及中性粒细胞比例正常,但肝肾功能及凝血指标异常。心电图提示窦性心动过速,心肌酶谱提示肌红蛋白130ng/mL轻度升高,而血气分析正常,尽管此时患者氧分压仅46mmHg。
影像学检查:

1、大叶性肺炎
优先考虑此诊断,支持证据包括:青年男性起病急、病程短;以咳嗽、发热等呼吸道感染症状为主,伴痰中带血、乏力(符合社区获得性肺炎特点);胸部CT见右肺大片实变影及支气管充气征;入院时已出现呼吸衰竭、多脏器功能不全征象,需警惕重症肺炎。目前需进一步明确病原菌(如肺炎链球菌、克雷伯菌等)。
2、干酪性肺炎(结核相关)
需鉴别考虑,支持点为青年男性(结核好发年龄)、咳嗽/发热/痰中带血等表现、胸部CT多叶段实变影;但起病时间短,不符合结核的生长规律,暂不优先考虑。
3、肺栓塞
存在部分支持依据(起病急、症状、D-二聚体升高),但心电图/心脏彩超无异常、无下肢不对称水肿、胸部CT未提示右肺动脉增宽,支持证据不足,暂不优先考虑。
4、非感染性病变(血管炎、肺癌)
虽有综合症状、CT表现及多脏器不全支持,但血管炎多非单肺受累且咯血表现与影像不符,肺癌起病时间短、影像与肺炎型肺癌存在差异,目前支持依据不足,需进一步排查。
1、入住RICU
治疗方案:(1)止血;(2)抗感染:亚胺培南西司他丁钠+莫西沙星,经鼻高流量辅助通气;(3)完善检查,ANA、ANCA、血培养、凝血因子、易栓症筛查等;(4)保护脏器功能、严密监测以及稳定生命体征;(5)维持内环境稳定
2、病情加重
入住RICU 3小时后,病情急转直下:咯血不止,气管插管有创机械通气。
3、调整治疗方案
(1)加强止血,同时输注血浆、凝血因子、红细胞悬液;(2)气管镜下右侧肺球囊封堵;(3)气道内血性分泌物送培养;(4)深静脉穿刺扩容;(5)尿培养;(6)沟通拟启动ECMO,同时开展紧急全院会诊
4、病情思考
能够引起全身多系统出血的病因:1)血管异常;2)凝血功能异常;3)血小板疾病。
5、转机出现
(1)灌洗液培养及血培养结果报阳,“气单胞菌”。
(2)“气单胞菌”剖析

查看更多
专家点评
本病例为一例极危重的社区获得性肺炎(CAP)合并多器官功能衰竭的成功救治案例,其诊疗过程为我们提供了多重重要启示。
首先,在诊断思路上应建立清晰的鉴别框架。接诊CAP患者时,首要任务是鉴别其是否为真正的社区感染,并依据是否累及呼吸与循环等生命支持系统,快速区分普通CAP与重症CAP,后者直接决定救治的强度与紧迫性。本例患者病情迅猛进展,伴多器官出血性表现,明确属于重症CAP。
其次,病原学的预判需基于深入的个体化病史与临床特征分析。该患者为既往体健的青年,但有吸烟、饮酒、熬夜等不良习惯,关键线索在于发病前有河道游泳史。结合其快速出现的全身多系统出血性特征,高度提示感染可能由具有血管内皮侵袭性的病原体引起,如肺炎克雷伯菌、嗜水气单胞菌、金黄色葡萄球菌、溶血性链球菌等。这要求临床医生必须详尽追溯流行病学暴露史。
再者,救治成功依赖于三位一体的核心策略——强效抗感染、精准器官支持与快速病原确认。
1. 经验性抗感染治疗:针对疑似毒力强、进展快的病原体,初始治疗需广覆盖、足强度。本例即选用了碳青霉烯类联合氟喹诺酮类的方案。
2. 恰当的器官功能支持:对于重症CAP,及时、分级的呼吸支持以及循环、凝血等系统的支持是维持生命、为抗感染治疗赢得时间的基础。
3. 快速的病原学诊断:在传统培养方法滞后时,对下呼吸道标本进行宏基因组二代测序,能极速明确病原体,指导后续精准治疗。即便使用敏感药物,对于此类重症感染,监测并确保有效的血药浓度与组织浓度亦是治疗关键。
综上,本病例的救治经验提示,面对极危重CAP,必须整合详细的病史挖掘、基于临床特征的病原学预判、早期强效的经验性治疗、及时的器官支持以及利用现代技术快速明确病原,形成一套完整、敏捷的诊疗闭环,方能最大程度改善患者预后。